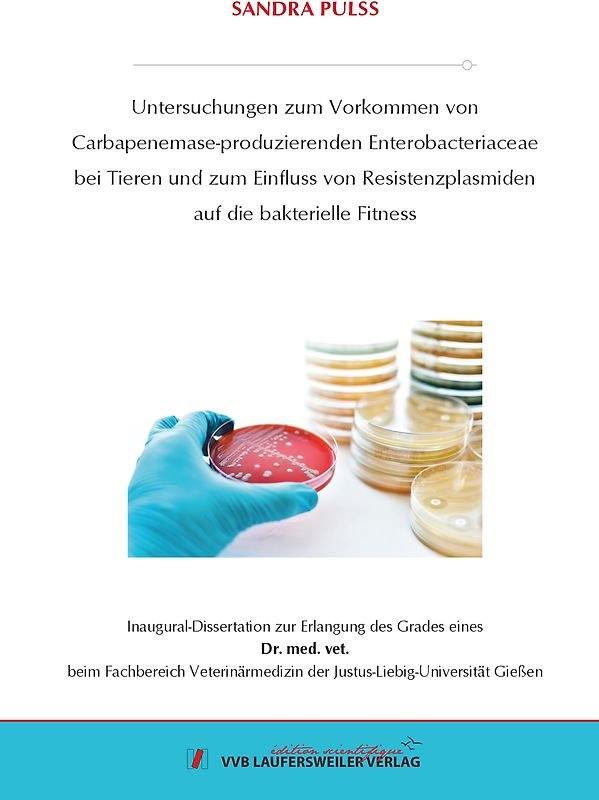
Untersuchungen zum Vorkommen von Carbapenemase-produzierenden Enterobacteriaceae bei Tieren und zum Einfluss von Resistenzplasmiden auf die bakterielle Fitness

iPhoneAlle anzeigen
iPhone 11iPhone 11 ProiPhone 11 Pro MaxiPhone 12iPhone 12 ProiPhone 12 Pro MaxiPhone 12 miniiPhone 13iPhone 13 ProiPhone 13 Pro MaxiPhone 13 miniiPhone 14iPhone 14 PlusiPhone 14 ProiPhone 14 Pro MaxiPhone 15iPhone 15 PlusiPhone 15 ProiPhone 15 Pro MaxiPhone 16iPhone 16 PlusiPhone 16 ProiPhone 16 Pro MaxiPhone 16eiPhone 5iPhone 5CiPhone 5SiPhone 6iPhone 6 PlusiPhone 6SiPhone 6S PlusiPhone 7iPhone 7 PlusiPhone 8iPhone 8 PlusiPhone SEiPhone SE 2020iPhone SE 2022iPhone XiPhone XRiPhone XSiPhone XS Max
NokiaAlle anzeigen
108 Reihe220 Reihe225 Reihe2600 classic Reihe2680 slide Reihe2710 Reihe3120 classic Reihe3220 Reihe500 Reihe515 Reihe5230 Reihe603 Reihe6131 Reihe6200 Reihe6300 Reihe6500 Reihe6700 Reihe700 Reihe7200 Reihe8310 ReiheAshaC1C2C3C5C6C7E51E52E6E63E65E7E71E72N73N8N9N95N97Nokia 3Nokia 4.2Nokia 5Nokia 6Nokia 7Nokia 8SiroccoWeitere ModelleXX2X3X6XLXpressMusic
Galaxy A-SerieAlle anzeigen
Galaxy A12Galaxy A13Galaxy A13 5GGalaxy A14Galaxy A15Galaxy A16Galaxy A17 5GGalaxy A20eGalaxy A21Galaxy A22Galaxy A23Galaxy A24Galaxy A25Galaxy A26 5GGalaxy A3Galaxy A32Galaxy A33Galaxy A34Galaxy A35Galaxy A36 5GGalaxy A37Galaxy A40Galaxy A41Galaxy A42Galaxy A50Galaxy A51Galaxy A52Galaxy A53Galaxy A54Galaxy A55Galaxy A56 5GGalaxy A70Galaxy A71Galaxy A72
Redmi SeriesAlle anzeigen
Redmi 10Redmi 13CRedmi 15 5GRedmi Note 10Redmi Note 10 ProRedmi Note 11Redmi Note 11 ProRedmi Note 11 Pro Plus 5GRedmi Note 11sRedmi Note 12Redmi Note 12 5GRedmi Note 12 ProRedmi Note 12 Pro 5GRedmi Note 12 Pro PlusRedmi Note 13Redmi Note 13 5GRedmi Note 13 ProRedmi Note 13 Pro PlusRedmi Note 14Redmi Note 14 Pro PlusRedmi Note 8Redmi Note 8 ProRedmi Note 9Redmi Note 9 Pro
- Startseite
Bücher Wissen & Bildung Naturwissenschaft, Medizin, Informatik, Technik Medizin Veterinärmedizin Untersuchungen zum Vorkommen von Carbapenemase-produzierenden Enterobacteriaceae bei Tieren und zum Einfluss von Resistenzplasmiden auf die bakterielle Fitness
Derzeit nicht verfügbar
Handgeprüfte Gebrauchtware
Bis zu 50 % günstiger als neu
Der Umwelt zuliebe
Untersuchungen zum Vorkommen von Carbapenemase-produzierenden Enterobacteriaceae bei Tieren und zum Einfluss von Resistenzplasmiden auf die bakterielle Fitness
Sandra Pulss (Broschiert, Deutsch)
★★★★★
☆☆☆☆☆ Keine Bewertungen vorhanden
Optischer Zustand
Beschreibung
Carbapenemase-produzierende Enterobacteriaceae stellen ein großes Problem in der Therapie von bakteriellen Infektionen dar. Besonders nosokomiale Infektionen mit diesen Erregern treten sowohl in der Human- wie auch in der Tiermedizin immer häufiger auf. Um einen Überblick über das Auftreten multiresistenter Enterobacteriaceae zu erlangen, sind Screening-Studien unerlässlich.
Zur Abklärung der… Ausbreitung von Carbapenemase-produzierenden Enterobacteriaceae in der Tiermedizin wurden von Juni 2012 bis Dezember 2016 insgesamt 19.025 E. coli, 1.607 Klebsiella spp. und 570 Enterobcter spp. plus 367 archivierte ESBL-/AmpC-produzierende Enterobacteriaceae aus früheren Untersuchungen von Schweinen (n = 10.899), Rindern (n = 1.889), kleinen Wiederkäuern (n = 246), Vögeln (n=132), Hunden (n=3.775), Katzen (n = 932), Pferden (n = 2.573), Nagetieren und Kaninchen (n = 428), Zoo- und Wildtiere (n = 644) und anderen (n = 51) auf eine Carbapenem-Resistenz untersucht. Das Probenmaterial stammte von Einsendungen ca. 1500 verschiedener veterinärmedizinischer Einrichtungen in unterschiedlichen Regionen in Deutschland (externe Kliniken), sowie aus den Kliniken für Pferde, Wiederkäuer, Schweine und Kleintiere und aus dem Institut für Veterinär-Pathologie der JLU Gießen (interne Kliniken).
Phänotypisch Carbapenem-non-sensible Isolate wurden mittels PCR auf die Carbapenemasegene blaNDM like, blaVIM like, blaKPC-like und blaOXA-48 like und im positiven Falle auf die ESBL- und AmpC-β Laktamasen blaCTX M like, blaSHV like, blaTEM like, blaOXA like, blaCMY like, blaDHA like, blaACC like und blaFOX like getestet.
Die OXA 48 like Carbapenemasen OXA-48 und OXA 181 konnten in 137 bzw. in zwei Fällen nachgewiesen werden.
Alle blaOXA-48-Gene wurden auf konjugativen, ca. 60 kb IncL-Plasmiden lokalisiert. Diese Plasmide wiesen eine Sequenzhomologie von bis zu 100 % zu in der Literatur beschriebenen IncL-Plasmiden aus der Humanmedizin auf. Die OXA-48-positiven Isolate stammen ausschließlich von Kleintieren und konnten nicht bei Nutztieren nachgewiesen werden.
In K. pneumoniae wurde diese Carbapenemase am häufigsten gefunden (n=86; 6,6 %), gefolgt von E. cloacae (n=28; 5 %), K. oxytoca (n=1; 0,3 %) und E. coli (n=22; 0,1 %). Bei den OXA-48-tragenden K. pneumoniae-Isolaten waren der ST11 und ST15, bei E. cloacae der ST506 und ST78 und bei E. coli der ST1196 besonders häufig vertreten. Nur 20 der 137 OXA-48-tragenden Isolate stammten von externen Tierarztpraxen. Die große Anzahl an OXA-48-positiven Isolaten aus der internen Kleintierklinik, die Ähnlichkeit der Plasmide hinsichtlich ihres Replikontyps und der Größe, das Sequenztypensprektrum und die Ergebnisse der Makrorestriktionsanalysen weisen auf eine hohe Klonalität von Isolaten innerhalb der verschiedenen Sequenztypen hin und indizieren eine nosokomiale Verbreitung entsprechender Isolate. Die Ähnlichkeit der OXA-48-Plasmide hinsichtlich ihres Replikontyps und der Größe sowie ihre in vitro gezeigten konjugativen Eigenschaften lassen zudem vermuten, dass eine Übertragung der Plasmide zwischen verschiedenen Spezies und/oder Sequenztypen stattgefunden hat. Die wiederholten Nachweise von Isolaten mit identischen Makrorestriktionsprofilen über lange Zeiträume von bis zu vier Jahren (K. pneumoniae ST15) könnten auf eine Persistenz in der Klinikumgebung hinweisen, wobei wiederhholte externe Einträge jedoch nicht ausgeschlossen werden können.
Die OXA-181-tragenden E. coli-Isolate stammen aus zwei unterschiedlichen Tieren aus einem italienischen Schweinebestand. Mittels MLST wurden der ST359 und ST641 ermittelt. Ein OXA-181-tragendes Isolat beherbergte zusätzlich die Colistin-Resistenzdeterminante MCR 1 und das Methyltransferasegen armA. Beide OXA-181-Plasmide besaßen außerdem das Quinolon-Resistenzgen qnrS1. Das Carbapenemase-Gen blaOXA 181 konnte auf einem ca. 50 kb großen, nicht-konjugativen IncX3-Plasmid nachgewiesen werden. Das Colistin-Resistenzgen mcr 1 wurde auf einem ca. 30 kb großen IncX4-Plasmid lokalisiert. Während in der Humanmedizin bereits OXA 181-tragende IncX3-Plasmide mit bis zu 100 % Sequenzhomologie zu den Funden dieser Studie beschrieben wurden, handelt es sich hier um den einzigen OXA 181-Nachweis in Schweinebeständen. Das nachgewiesene IncX4-Plasmid wies ebenfalls eine hohe Sequenzhomologie von bis zu 99,97 % zu bereits beschriebenen IncX4-Plasmiden auf. Die Kombination von OXA-181 und der Colistin-Resistenz MCR 1 in einem Bakterium wird hier das erste Mal beschrieben.
In den ergänzenden Untersuchungen zum Einfluss des OXA-48-Plasmids auf die Biofilmbildung konnte aufgrund differierender Biofilmexpression der Isolate sowohl mit Resistenzplasmid (Wildtypstamm) als auch ohne OXA-48-Plasmid (Plasmid-gecurte Variante) keine Aussage über einen einheitlichen Effekt des Resistenzplasmids auf die Fähigkeit zur Biofilmbildung gegeben werden. Dies deutet auf sehr komplexe Mechanismen der Biofilmbildung hin.
Auf die Sterblichkeit der Wachsmottenlarven konnte in den hier beschriebenen Untersuchungen kein statistisch signifikanter Einfluss des OXA-48-Plasmids ermittelt werden. Zusammenfassend betrachtet lag die Letalität der Wachsmottenlarven, die mit Isolaten mit oder ohne Resistenzplasmid infiziert wurden, im selben Bereich.
Diese Arbeit konnte einen Überblick über die Verbreitung Carbapenemase-produzierender Enterobacteriaceae bei Tieren in Deutschland schaffen und Aufschluss über die nosokomiale Ausbreitung von verschiedenen Spezies und Sequenztypen mit einem OXA-48-Plasmid gleicher Größe und identischen Replikontyps in einer Tierklinik geben. Für die gezielte Bekämpfung von Tierklinik-assoziierten Infektionsgeschehen sind, analog zur Humanmedizin, Surveillance-Studien von großer Bedeutung. Die Kenntnis zur molekularen Epidemiologie von Carbapenemase-produzierenden Bakterien und deren Resistenzplasmiden ist eine wesentliche Voraussetzung für die Implementierung bzw. Optimierung von präventiven Hygienemaßnahmen in Tierkliniken. Es konnte gezeigt werden, dass Carbapenemase-Bildner aus der Veterinär- und Humanmedizin wesentliche gemeinsame Eigenschaften aufweisen. Dies verdeutlicht einmal mehr, dass der globalen Antibiotikaresistenz-Problematik nur mit einem „One Health“-Ansatz begegnet werden kann. Dieses Produkt haben wir gerade leider nicht auf Lager.
Handgeprüfte Gebrauchtware
Bis zu 50 % günstiger als neu
Der Umwelt zuliebe
Technische Daten
Erscheinungsdatum
03.12.2021
Sprache
Deutsch
EAN
9783835969995
Herausgeber
VVB Laufersweiler Verlag
Serien- oder Bandtitel
Edition Scientifique
Sonderedition
Nein
Autor
Sandra Pulss
Seitenanzahl
167
Einbandart
Broschiert
Einbandart Details
Paperback
Schlagwörter
Bakterien, Resistenz, Plasmide
Thema-Inhalt
MZAB - Tiermedizin: Forschung
MZP - Tiermedizin: Pharmakologie
MZMP - Tiermedizin: Bakteriologie, Virologie, Parasitologie
MZC - Tiermedizin: Klein- und Haustiere
MZD - Tiermedizin: Groß- und Nutztiere
MZM - Tiermedizin: Infektionskrankheiten und Therapeutika
Höhe
210 mm
Breite
14.8 cm
-.-
★★★★★
☆☆☆☆☆ Leider noch keine Bewertungen
Leider noch keine Bewertungen
Sicher bei rebuy kaufen
Schreib die erste Bewertung für dieses Produkt!
Wenn du eine Bewertung für dieses Produkt schreibst, hilfst du allen Kund:innen, die noch überlegen, ob sie das Produkt kaufen wollen. Vielen Dank, dass du mitmachst!
Sicher bei rebuy kaufen

